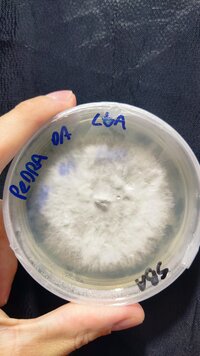

-
 IMG-20231128-WA0026.jpg419.5 KB · Visualizações: 77
IMG-20231128-WA0026.jpg419.5 KB · Visualizações: 77 -
 IMG_20240103_214504.jpg622.8 KB · Visualizações: 69
IMG_20240103_214504.jpg622.8 KB · Visualizações: 69 -
 IMG_20240103_214443.jpg442.5 KB · Visualizações: 60
IMG_20240103_214443.jpg442.5 KB · Visualizações: 60 -
 images - 2024-01-03T214832.391.jpeg60.9 KB · Visualizações: 67
images - 2024-01-03T214832.391.jpeg60.9 KB · Visualizações: 67 -
 IMG-20231126-WA0033.jpg122.6 KB · Visualizações: 68
IMG-20231126-WA0033.jpg122.6 KB · Visualizações: 68 -
 IMG-20231126-WA0028.jpg106.3 KB · Visualizações: 67
IMG-20231126-WA0028.jpg106.3 KB · Visualizações: 67 -
 IMG-20231127-WA0087.jpg233.6 KB · Visualizações: 67
IMG-20231127-WA0087.jpg233.6 KB · Visualizações: 67 -
 IMG-20231127-WA0047.jpg399.1 KB · Visualizações: 65
IMG-20231127-WA0047.jpg399.1 KB · Visualizações: 65 -
 IMG-20231127-WA0089.jpg391.9 KB · Visualizações: 68
IMG-20231127-WA0089.jpg391.9 KB · Visualizações: 68 -
 IMG-20231128-WA0023.jpg112.7 KB · Visualizações: 71
IMG-20231128-WA0023.jpg112.7 KB · Visualizações: 71 -
 IMG_20231128_152931.jpg879.9 KB · Visualizações: 64
IMG_20231128_152931.jpg879.9 KB · Visualizações: 64 -
 IMG_20231128_163434.jpg1.3 MB · Visualizações: 68
IMG_20231128_163434.jpg1.3 MB · Visualizações: 68 -
 IMG_20231128_162825.jpg1.2 MB · Visualizações: 70
IMG_20231128_162825.jpg1.2 MB · Visualizações: 70 -
 IMG-20231222-WA0012.jpg179.7 KB · Visualizações: 66
IMG-20231222-WA0012.jpg179.7 KB · Visualizações: 66 -
 IMG_20240103_220658.jpg325.8 KB · Visualizações: 66
IMG_20240103_220658.jpg325.8 KB · Visualizações: 66 -
 IMG_20240101_145005.jpg1.2 MB · Visualizações: 68
IMG_20240101_145005.jpg1.2 MB · Visualizações: 68 -
 IMG_20240103_175405.jpg1.2 MB · Visualizações: 69
IMG_20240103_175405.jpg1.2 MB · Visualizações: 69 -
IMG_20240103_222523.jpg1.4 MB · Visualizações: 64
IMG_20240103_222523.jpg1.4 MB · Visualizações: 64 -
 IMG_20240103_223014.jpg813.4 KB · Visualizações: 63
IMG_20240103_223014.jpg813.4 KB · Visualizações: 63 -
 IMG_20240104_125109.jpg1.6 MB · Visualizações: 75
IMG_20240104_125109.jpg1.6 MB · Visualizações: 75 -
 IMG_20240104_125048.jpg1.7 MB · Visualizações: 69
IMG_20240104_125048.jpg1.7 MB · Visualizações: 69 -
 IMG_20240104_124535.jpg1.6 MB · Visualizações: 75
IMG_20240104_124535.jpg1.6 MB · Visualizações: 75 -
 IMG_20240104_121935.jpg630.5 KB · Visualizações: 69
IMG_20240104_121935.jpg630.5 KB · Visualizações: 69 -
 IMG_20240104_121930.jpg745.9 KB · Visualizações: 590
IMG_20240104_121930.jpg745.9 KB · Visualizações: 590 -
 IMG_20240104_121957.jpg570.8 KB · Visualizações: 70
IMG_20240104_121957.jpg570.8 KB · Visualizações: 70 -
 IMG_20240104_121926.jpg476.6 KB · Visualizações: 69
IMG_20240104_121926.jpg476.6 KB · Visualizações: 69 -
 IMG_20240104_122919.jpg880.9 KB · Visualizações: 65
IMG_20240104_122919.jpg880.9 KB · Visualizações: 65 -
 IMG_20240104_123425.jpg850.2 KB · Visualizações: 80
IMG_20240104_123425.jpg850.2 KB · Visualizações: 80 -
 IMG_20240104_194820.jpg1.2 MB · Visualizações: 65
IMG_20240104_194820.jpg1.2 MB · Visualizações: 65 -
 IMG_20240104_194805.jpg984 KB · Visualizações: 68
IMG_20240104_194805.jpg984 KB · Visualizações: 68
Teonanacatl.org
Aqui discutimos micologia amadora e enteogenia.
Cadastre-se para virar um membro da comunidade! Após seu cadastro, você poderá participar deste site adicionando seus próprios tópicos e postagens.
-
Por favor, leia com atenção as Regras e o Termo de Responsabilidade do Fórum. Ambos lhe ajudarão a entender o que esperamos em termos de conduta no Fórum e também o posicionamento legal do mesmo.
Completo Strain Pedra da Lua, minha 1ª domesticação com sucesso
- Adicionado por SpiritualMind
- Create date
-
- Tags
- psilocybe cubensis
Strain Pedra da Lua, minha 1ª domesticação com sucesso
